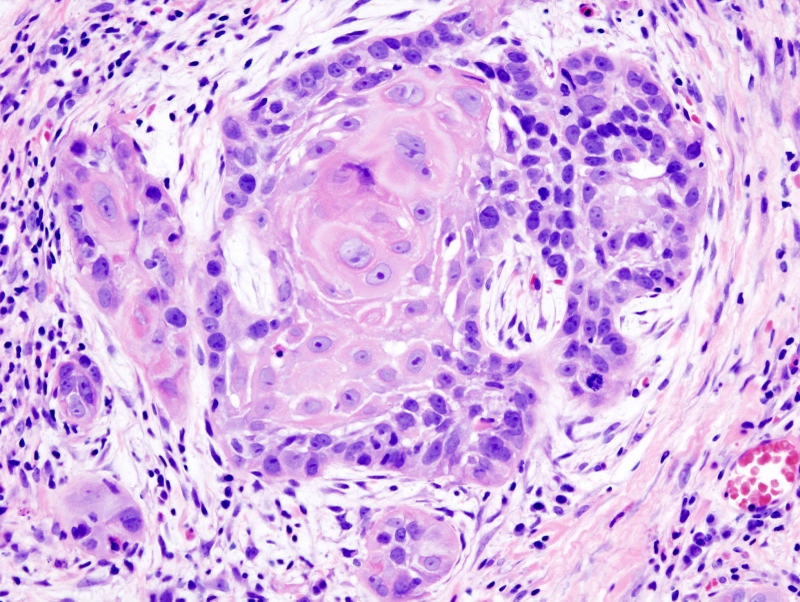
Tìm hiểu về  đột biến gen IDH1 và IDH2 ở các bệnh nhân ung thư 4

Tốt nghiệp Khoa Dược trường Đại học Nam Cần Thơ. Có nhiều năm kinh nghiệm công tác trong lĩnh vực Dược phẩm. Hiện đang giảng viên cho Dược sĩ tại Nhà thuốc Long Châu.
Tuyết Vĩ
14/08/2024
Mặc định
Lớn hơn
Gen IDH1 và IDH2 đóng vai trò quan trọng trong quá trình chuyển hóa năng lượng của tế bào. Bài viết dưới đây, Nhà thuốc Long Châu sẽ cung cấp những thông tin về đột biến gen IDH1 và IDH2 trên bệnh nhân ung thư mà nhiều người quan tâm.
IDH1 cũng như IDH2 là những gen được quan tâm rộng rãi trong lĩnh vực nghiên cứu y học, đặc biệt là trong việc hiểu rõ về bệnh tật liên quan đến tế bào u, như gliomas.
Họ enzyme isocitrate dehydrogenase (IDH) có ba đồng dạng, bao gồm IDH1 trong tế bào chất và peroxysomes, và IDH2 cùng IDH3 trong ty thể. Chúng đóng vai trò quan trọng trong quá trình chuyển hóa tế bào, như quá trình Phosphoryl hóa oxy hóa, sinh tổng hợp chất béo, và chuyển hóa Glutamine. IDH1 và IDH2 chuyển Isocitrate thành Alpha-ketoglutarate (αKG) và biến đổi NADP+ thành NADPH.

Gen IDH1 và IDH2 nằm trên nhiễm sắc thể (NST) khác nhau, lần lượt là 2q33.3 và 15q26.1. Các đột biến thường xuất hiện dưới dạng dị hợp tử trên tế bào soma, thường là đột biến điểm tại vùng hoạt động của enzyme IDH1 và IDH2.
Điều này dẫn đến thay thế axit amin Arginine ở vị trí 132 trên gen IDH1 và vị trí 172 hoặc 140 trên gen IDH2. Enzyme IDH bị đột biến biến đổi NADPH và αKG thành NADP+ và D2-hydroxyglutarate (D2HG). Sự tích tụ của D2HG ức chế nhiều enzym tham gia vào quá trình methyl hóa DNA, dẫn đến biến đổi trong biểu hiện gen và tăng sinh tế bào.
Xét nghiệm đột biến gen IDH là một dấu ấn quan trọng trong chẩn đoán, dự đoán tiên lượng sống và phản ứng điều trị cho bệnh nhân mắc Gliomas. Về mặt phân tử, Gliomas được phân thành hai loại: Có đột biến gen IDH (mutant-IDH) và không có đột biến (wild-type IDH).
Đột biến IDH1 và IDH2 thường thấy ở khoảng 80% các trường hợp Oligodendrogliomas và Astrocytomas grade II và III, cũng như GBM thứ phát, trong khi chỉ có 6% trường hợp GBM nguyên phát có đột biến gen IDH. Sự hiện diện của đột biến gen IDH giúp xác định nguồn gốc phát triển của u. Bệnh nhân Gliomas có đột biến gen IDH thường có triệu chứng đặc trưng như xuất hiện ở người trẻ, thường ở thùy trán, ít xâm lấn và có tiên lượng tốt hơn.
Đột biến gen IDH1 phổ biến nhất khi chiếm khoảng 90% tất cả các đột biến nhóm gen IDH, gây ra sự thay đổi axit amin từ Arginine thành Histidine (R132H). Ngoài IDH1 R132H, có các đột biến hiếm hơn trên gen IDH1 tại vị trí Arg132 như R132S, R132C, R132G và R132L, hoặc trên gen IDH2 tại vị trí Arg172 (R172K).

Nghiên cứu sinh học phân tử về Gliomas với đột biến nhóm gen IDH đã chỉ ra rằng những biến đổi này thường xuất hiện sớm trong quá trình hình thành và phát triển khối u. Các thay đổi phân tử khác bao gồm mất đoạn nhánh ngắn trên nhiễm sắc thể số 1 và mất đoạn nhánh dài trên nhiễm sắc thể số 19 (1p/19q co-deletion). Đồng thời, đột biến các gen CIC, FUBP và TERT thường được phát hiện ở Gliomas với tế bào thần kinh ít nhánh, trong khi đột biến các gen TP53 và ATRX thường xuất hiện ở Gliomas với tế bào hình sao.
Người mắc Gliomas có đột biến nhóm gen IDH thường có sự gia tăng methyl hóa vùng promoter của gen MGMT, điều này giúp tăng hiệu quả của các loại thuốc hóa trị alkyl hóa như Temozolomide (TMZ).
Đột biến nhóm gen IDH là một dấu ấn sinh học có giá trị cao trong việc chẩn đoán phân biệt các dạng Gliomas khác nhau. Như đã đề cập, đột biến nhóm gen IDH chủ yếu được phát hiện ở các Gliomas grade II, III và u nguyên bào thần kinh đệm thứ phát (secondary GBM).
Thêm vào đó, trong trường hợp lâm sàng phù hợp của nhóm GBM, việc phát hiện đột biến gen IDH có thể gợi ý rằng đây là một trường hợp u nguyên bào thần kinh thứ phát, chuyển từ một dạng Gliomas grade thấp.
Nghiên cứu của Sanson và Parsons cho thấy rằng sự hiện diện của đột biến nhóm gen IDH là một dấu ấn sinh học dự báo tiên lượng tốt cho bệnh nhân gliomas. Trái lại, nếu bệnh nhân không có đột biến nhóm gen IDH, đặc biệt ở Gliomas grade II và III, tiên lượng sống thường khá xấu.
Sự có mặt của đột biến nhóm gen IDH không chỉ ảnh hưởng đến quyết định điều trị mà còn tác động đến tiên lượng sau điều trị. Một nghiên cứu lớn do Cairncross và đồng nghiệp thực hiện đã chỉ ra rằng bệnh nhân có đột biến nhóm gen IDH điều trị kết hợp hóa xạ trị có thời gian sống trung bình cao hơn đáng kể so với nhóm chỉ điều trị bằng xạ trị (9,4 năm so với 5,7 năm). Trong khi đó, ở nhóm không có đột biến nhóm gen IDH, không có sự chênh lệch đáng kể giữa hai phương pháp điều trị (1,3 và 1,8 năm).

Theo WHO năm 2016, khuyến cáo xét nghiệm đột biến gen IDH1 và IDH2 cho tất cả bệnh nhân Gliomas grade II – III và GBM phải được chẩn đoán trước 55 tuổi. Đột biến phổ biến nhất của IDH1 là R132H có thể được phát hiện thông qua xét nghiệm hóa mô miễn dịch (IHC). Các đột biến khác của gen IDH1 và IDH2 có thể được phát hiện bằng phương pháp giải trình tự DNA.
Xét nghiệm tìm đột biến IDH1 R132H bằng IHC là phương pháp chẩn đoán được ưa chuộng nhờ vào độ nhạy và độ đặc hiệu cao. So với giải trình tự DNA, IHC có nhiều ưu điểm như cân bằng giữa hiệu quả và chi phí, và khả năng phát hiện cao ngay cả khi chỉ có một số ít tế bào u mang đột biến.
IHC đã được chứng minh có độ nhạy và độ đặc hiệu cao hơn giải trình tự DNA trong nhiều nghiên cứu, nhưng chỉ phát hiện được đột biến R132H trên gen IDH1. Do đó, nếu kết quả IHC âm tính trên các mẫu mô grade thấp hoặc nghi ngờ GBM thứ phát, cần thực hiện xét nghiệm giải trình tự gen IDH1 và IDH2.
Các phương pháp giải trình tự DNA cho nhóm gen IDH bao gồm giải trình tự Sanger, PCR và giải trình tự gen thế hệ mới. Phương pháp được chọn tùy thuộc vào trang thiết bị và chuyên môn của từng phòng xét nghiệm, cũng như sở thích và hiểu biết của bác sĩ lâm sàng.
Hy vọng bài viết trên đây đã giúp bạn hiểu hơn về đột biến gen IDH1 và IDH2 trên các bệnh nhân ung thư cùng những thông tin liên quan.
Xem thêm: Gen lặn là gì? Tổng hợp các bệnh di truyền gen lặn nguy hiểm
Dược sĩ Đại họcNguyễn Thị Thảo Nguyên
Tốt nghiệp Khoa Dược trường Đại học Nam Cần Thơ. Có nhiều năm kinh nghiệm công tác trong lĩnh vực Dược phẩm. Hiện đang giảng viên cho Dược sĩ tại Nhà thuốc Long Châu.